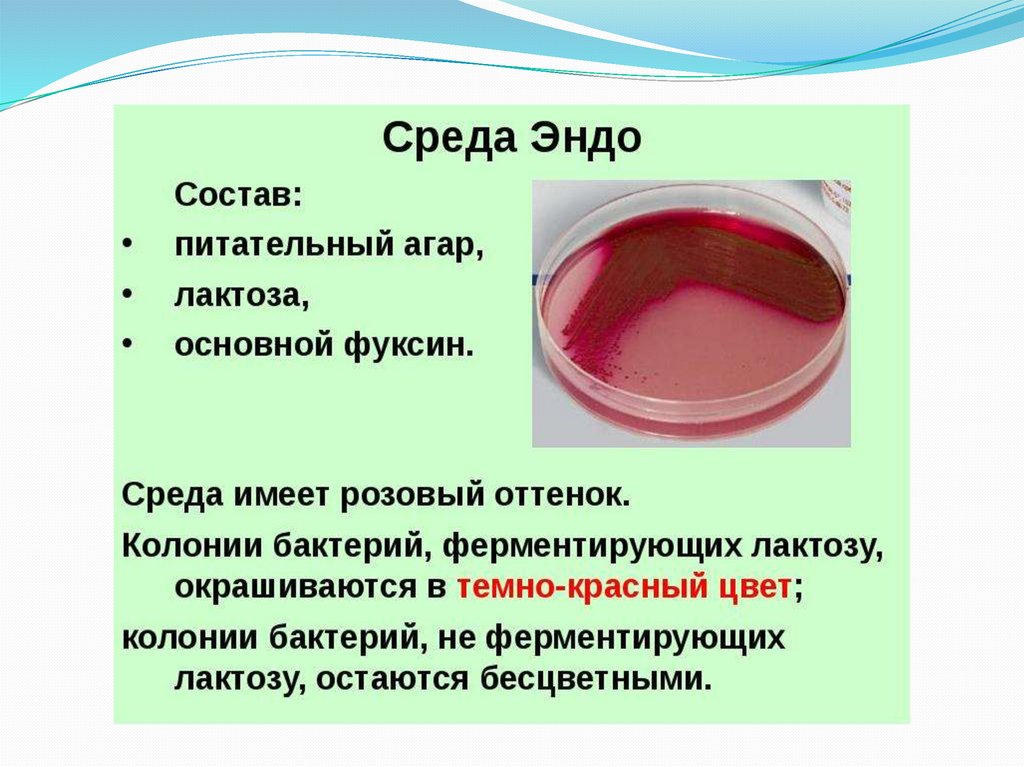
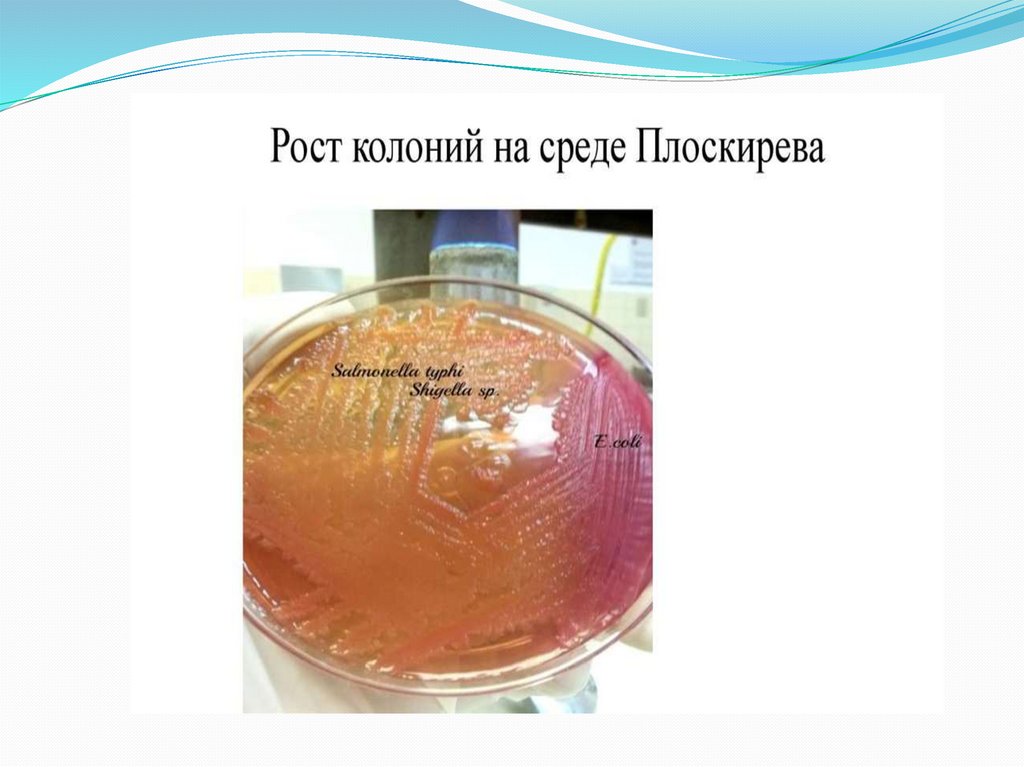
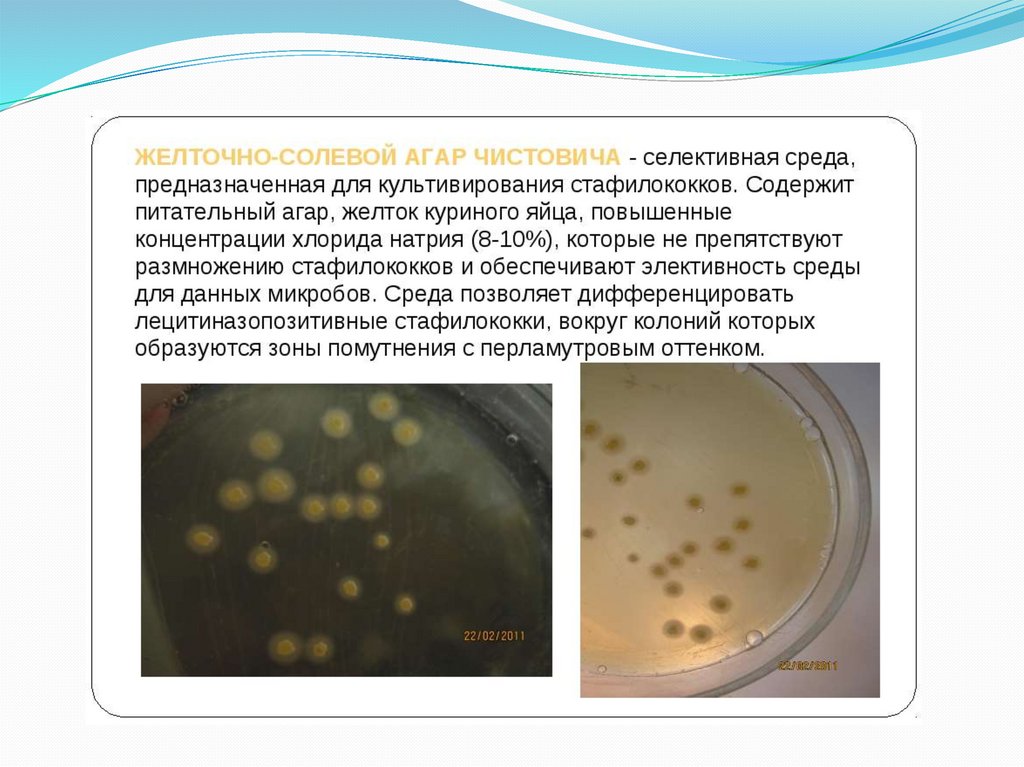
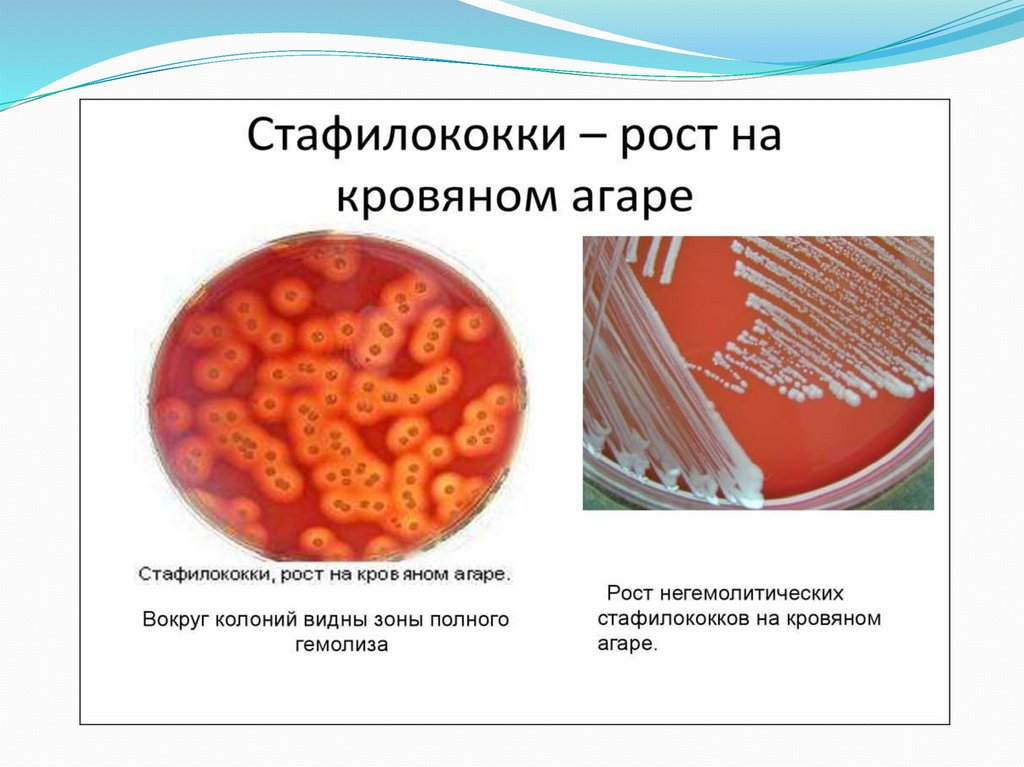
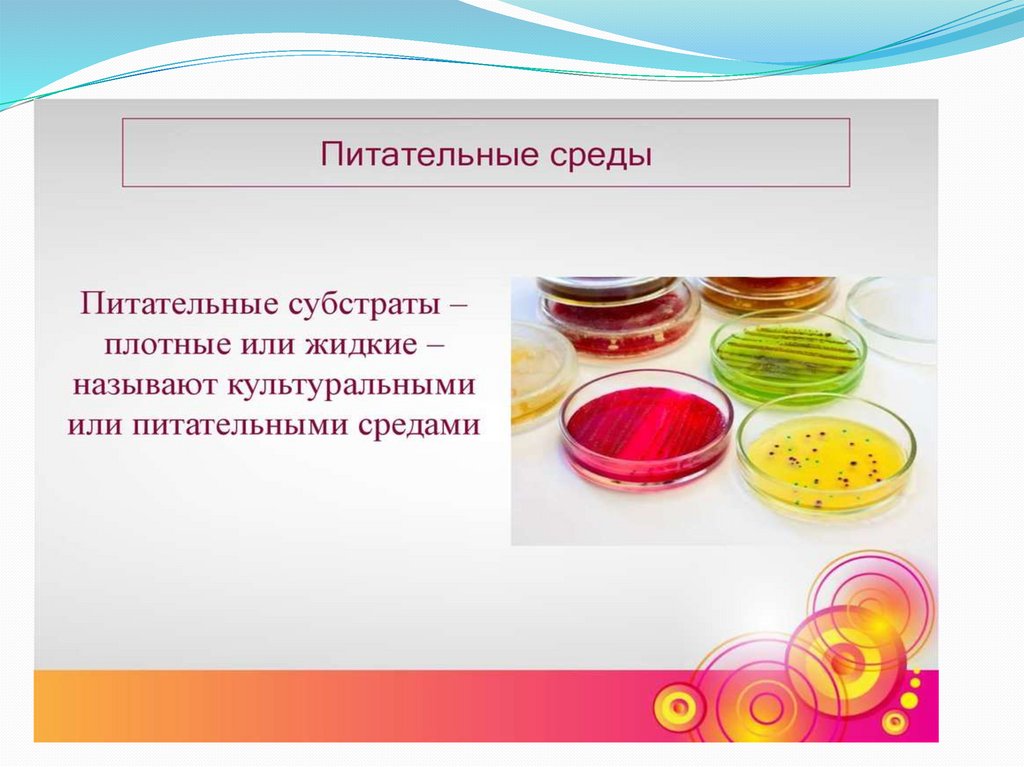
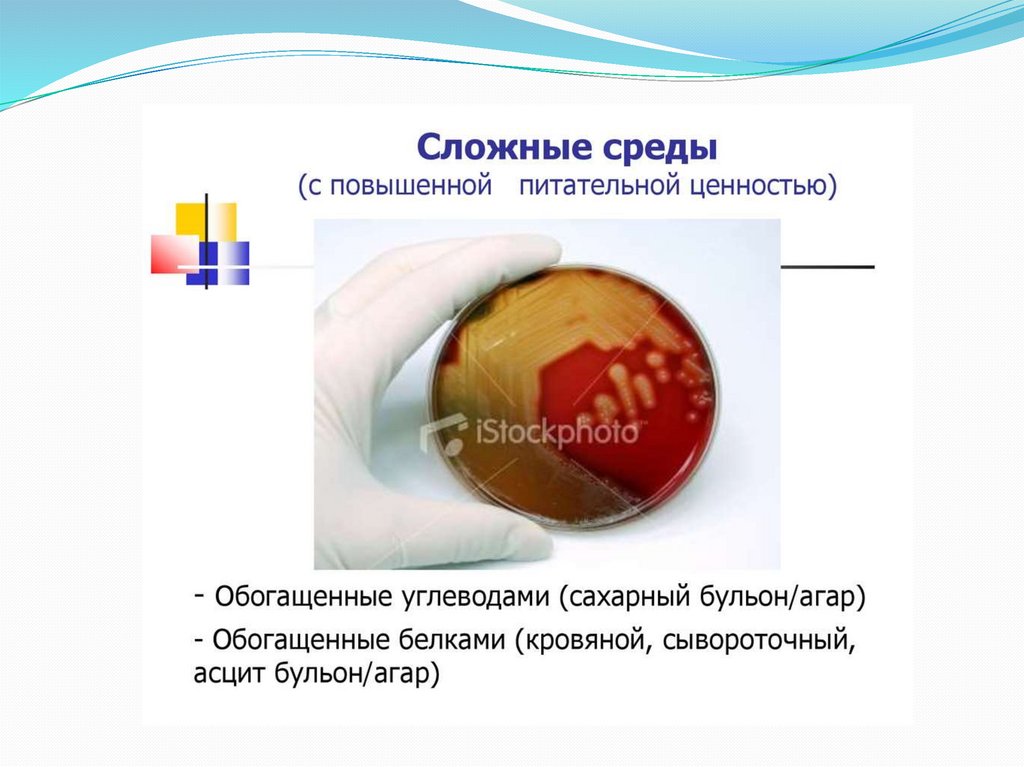
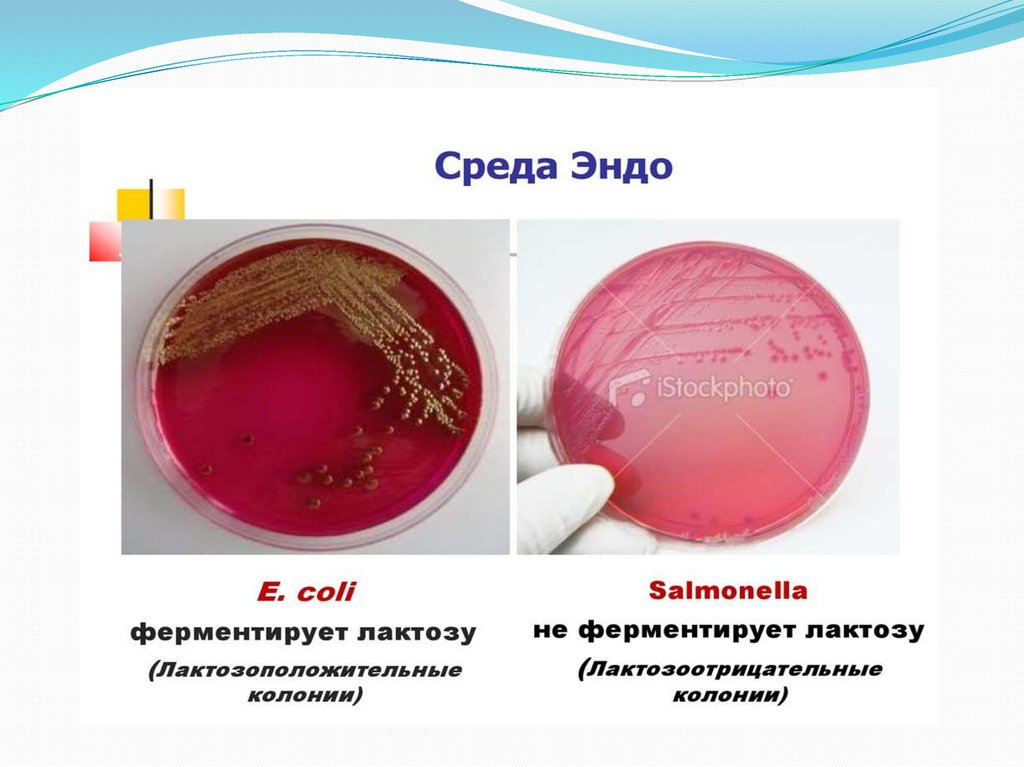
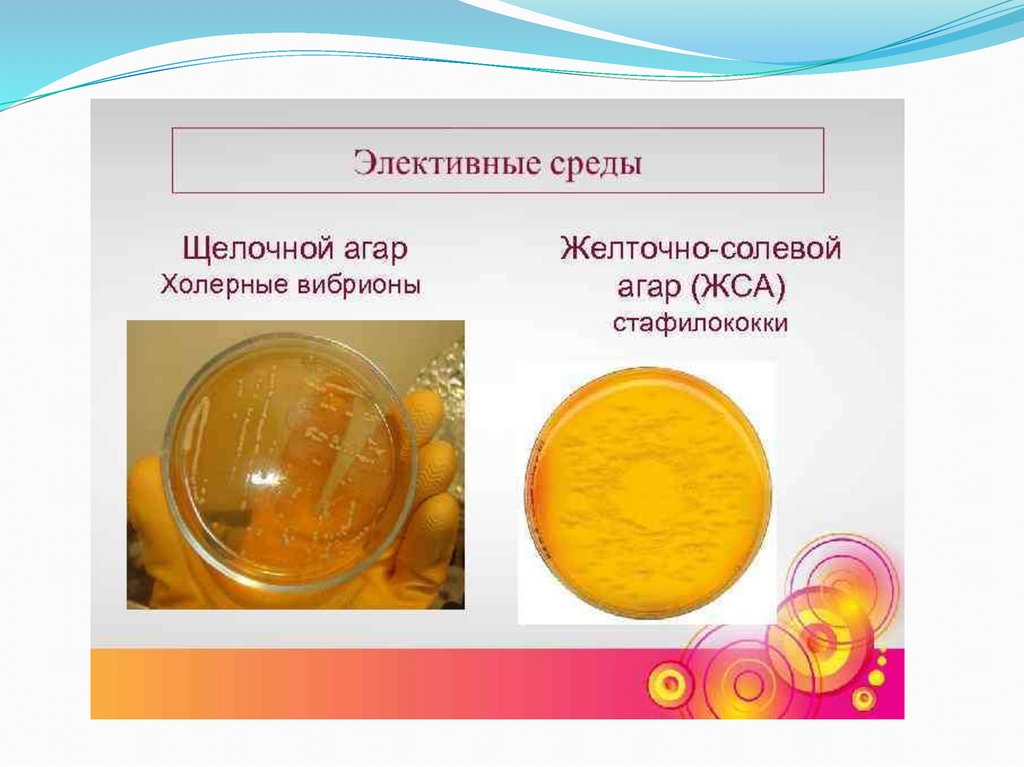
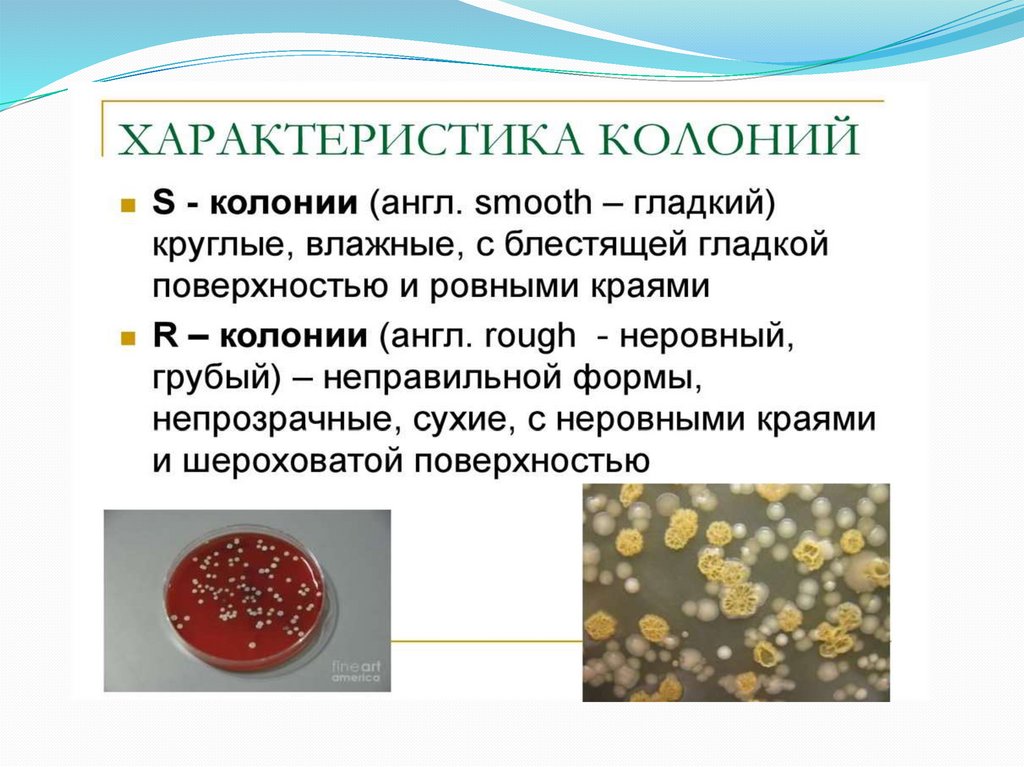
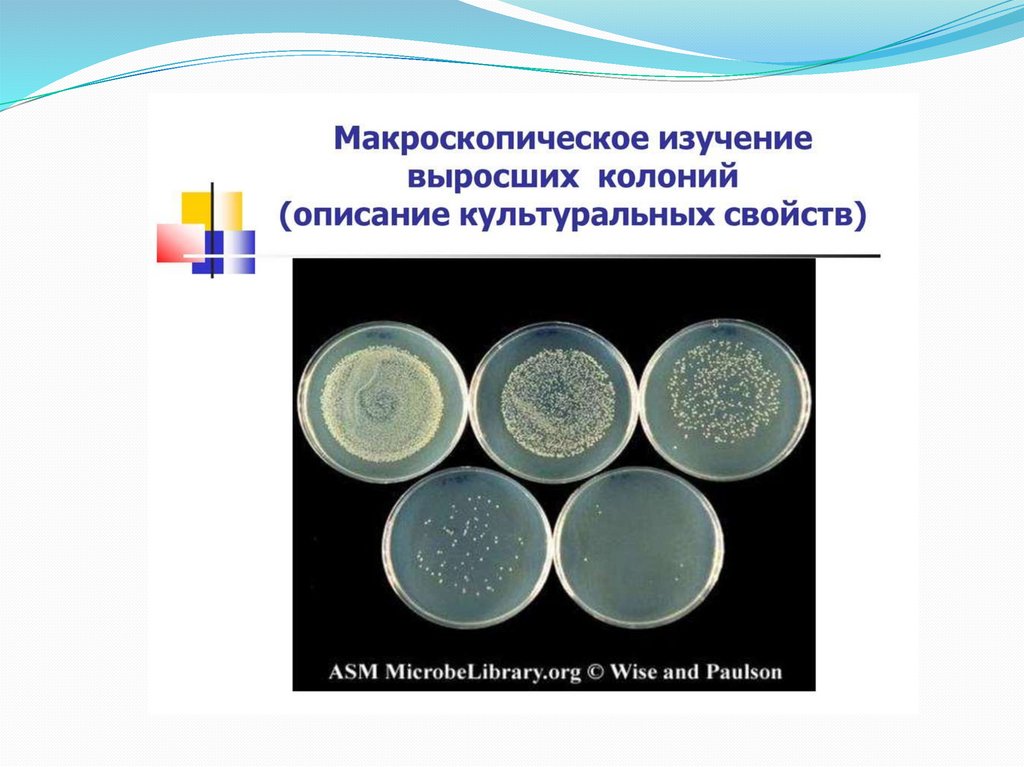

Похожие презентации:
Физиология микроорганизмов
1.
ФИЗИОЛОГИЯМИКРООРГАНИЗМОВ
ДЛЯ ЛЕЧЕБНОГО И ПЕДИАТРИЧЕСКОГО
ФАКУЛЬТЕТА
К.М.Н. ДОЦЕНТ КАФЕДРЫ МИКРОБИОЛОГИИ СОКОВНИНА С.В.
2.
План лекцииХимический состав бактерий
Питание бактерий
Дыхание бактерий
Рост и размножение бактерий
Питательные среды, их классификация.
3.
4.
5.
6.
7.
8.
Химический состав бактерийВода – осн. компонент, 80% ее массы.
Белки – (40-60% сухой массы) определяют главные биол.
свойства бактерий. МО содержат более 2000 разл.белков,
находящихся в структурных компонентах и участвующих в
процессах метаболизма.
Углеводы –простые вещества (моно- и дисахариды) и
комплексн.соед-ми. Полисахариды (ПС) входят в состав
капсул. Внутриклеточные ПС (крахмал, гликоген) являются
запасными питат. веществами.
Липиды - входят в состав ЦПМ, КС. Могут выполнять в
цитоплазме роль запасных питательных веществ. Это
фосфолипиды, жирные кислоты и глицериды. Макс. кол-во
липидов(до 40%), содержат микобактерии tbc.
Минеральные вещества – макро - Р, К, Na, S, Fe, Ca, Mg;
микро – Zn, Cu, Co, Ba, Mn. Участвуют в регуляции осмот.
давления, рН, ОВ -потенциала, активируют ферменты, сами
входят в состав ферментов, витаминов и структурных
элементов бактериальной клетки (БК).
9.
10.
11.
12.
13.
14.
Типы питания бактерийФакторы
роста
(ФР)
микроорганизмы
синтезировать не могут, их добавляют в питательные
среды. К ФР относят аминокислоты, необходимые
для построения белков, пурины и пиримидины,
необходимые для образования нуклеиновых кислот,
витамины, входящие в состав некоторых ферментов.
Для обозначения отношения МО к ФР используют
термины ауксотрофы и прототрофы.
Ауксотрофы нуждаются в 1 или нескольких ФР.
Прототрофы
могут
сами
синтезировать
необходимые для роста соединения.
15.
Механизм питанияПоступление различных веществ
в бак.клетку зависит
1. от величины и растворимости их
молекул в липидах и воде
2. рН среды
3. концентрации веществ
4. различных факторов проницаемости
мембран и др.
16.
17.
18.
19.
20.
21.
22.
23.
24.
25.
6 классов ферментов1.оксидоредуктазы — окислительно-восстановительные
ферменты (дегидрогеназы, оксидазы и др.);
2.трансферазы, переносящие отд.радикалы и атомы от одних
соединений к другим;
3.гидролазы, ускоряющие реакции гидролиза, т.е.
расщепления веществ на более простые с присоединением
молекул воды (эстеразы, фосфатазы, глюкозидазы);
4.лиазы, отщепляющие от субстратов химические группы
негидролитическим путем (карбоксилазы и др.);
5.изомеразы, превращающие органические соединения в их
изомеры (фосфогексоизомераза и др.);
6. лигазы, или синтетазы, ускоряющие синтез сложных
соединений из более простых (аспарагинсинтетаза, глюаминсинтетаза и др.)
26.
27.
28.
29.
30.
31.
32.
33.
34.
35.
36.
37.
38.
39.
40.
41.
42.
43.
44.
45.
46.
47.
48.
49.
50.
51.
52.
53.
54.
55.
56.
57.
58.
59.
60.
61.
62.
63.
64.
65.
66.
67.
68.
69.
70.
71.
72.
73.
74.
75.
76.
77.
78.
79.
80.
81.
82.
Делениюклеток
предшествует
репликация
бактериальной
хромосомы по полуконсервативному типу (двуспиральная цепь ДНК
раскрывается и каждая нить достраивается комплементарной нитью),
приводящая к удвоению молекул ДНК бактериального ядра —
нуклеотида. Репликация хромосомной ДНК осуществляется от
начальной точки ori (от англ. origin- начало). Хромосома БК связана в
области ori с ЦПМ. Репликация ДНК катализируется ДНКполимеразами. Сначала происходит раскручивание (деспирализация)
двойной цепи ДНК, в результате чего образуется репликативная вилка
(разветвленные цепи); одна из цепей достраиваясь, связывает
нуклеотиды от 5'- к 3'- к концу, другая – достраивается посегментарно.
83.
Репликация ДНК происходит в 3 этапа:1.инициализация 2. элонгация 3. терминация.
Образовавшиеся в результате репликации 2 хромосомы
расходятся, чему способствует увеличение размеров растущей клетки:
прикрепленные к ЦПМ хромосомы, по мере увеличения объема
клетки удаляются друг от друга. Окончательное их обособление
завершается образованием перетяжки или перегородки деления.
Клетки с перегородкой деления расходятся в результате действия
аутолитических ферментов, разрушающих сердцевину перегородки
деления. Аутолиз при этом происходит неравномерно: делящиеся
клетки в одном участке остаются связанными частью КС в области
перегородки деления. Такие клетки располагаются под углом друг к
другу
84.
Размножение бактерий в жидкой питательнойсреде
Бактерии, засеянные в определенный
объем
питательной
среды,
размножаются,
потребляют
питательные вещества, что приводит к
истощению питательной среды и
прекращению роста бактерий.
85.
86.
При размножении бактерий в жидкой питательной средеможно наблюдать последовательную смену фаз
87.
88.
89.
90.
91.
92.
93.
94.
95.
96.
97.
98.
99.
100.
101.
102.
103.
104.
105.
106.
107.
108.
109.
110.
111.
Принципы культивирования бактерийВыделение м/о из различных
материалов и получение чистых
культур необходимо для диагностики
заболеваний, в производстве вакцин,
антибиотиков и других БАВ. Для этого
необходимы условия:
-температура
-время культивирования
-значение рН среды
-состав среды

Биология
Биология








